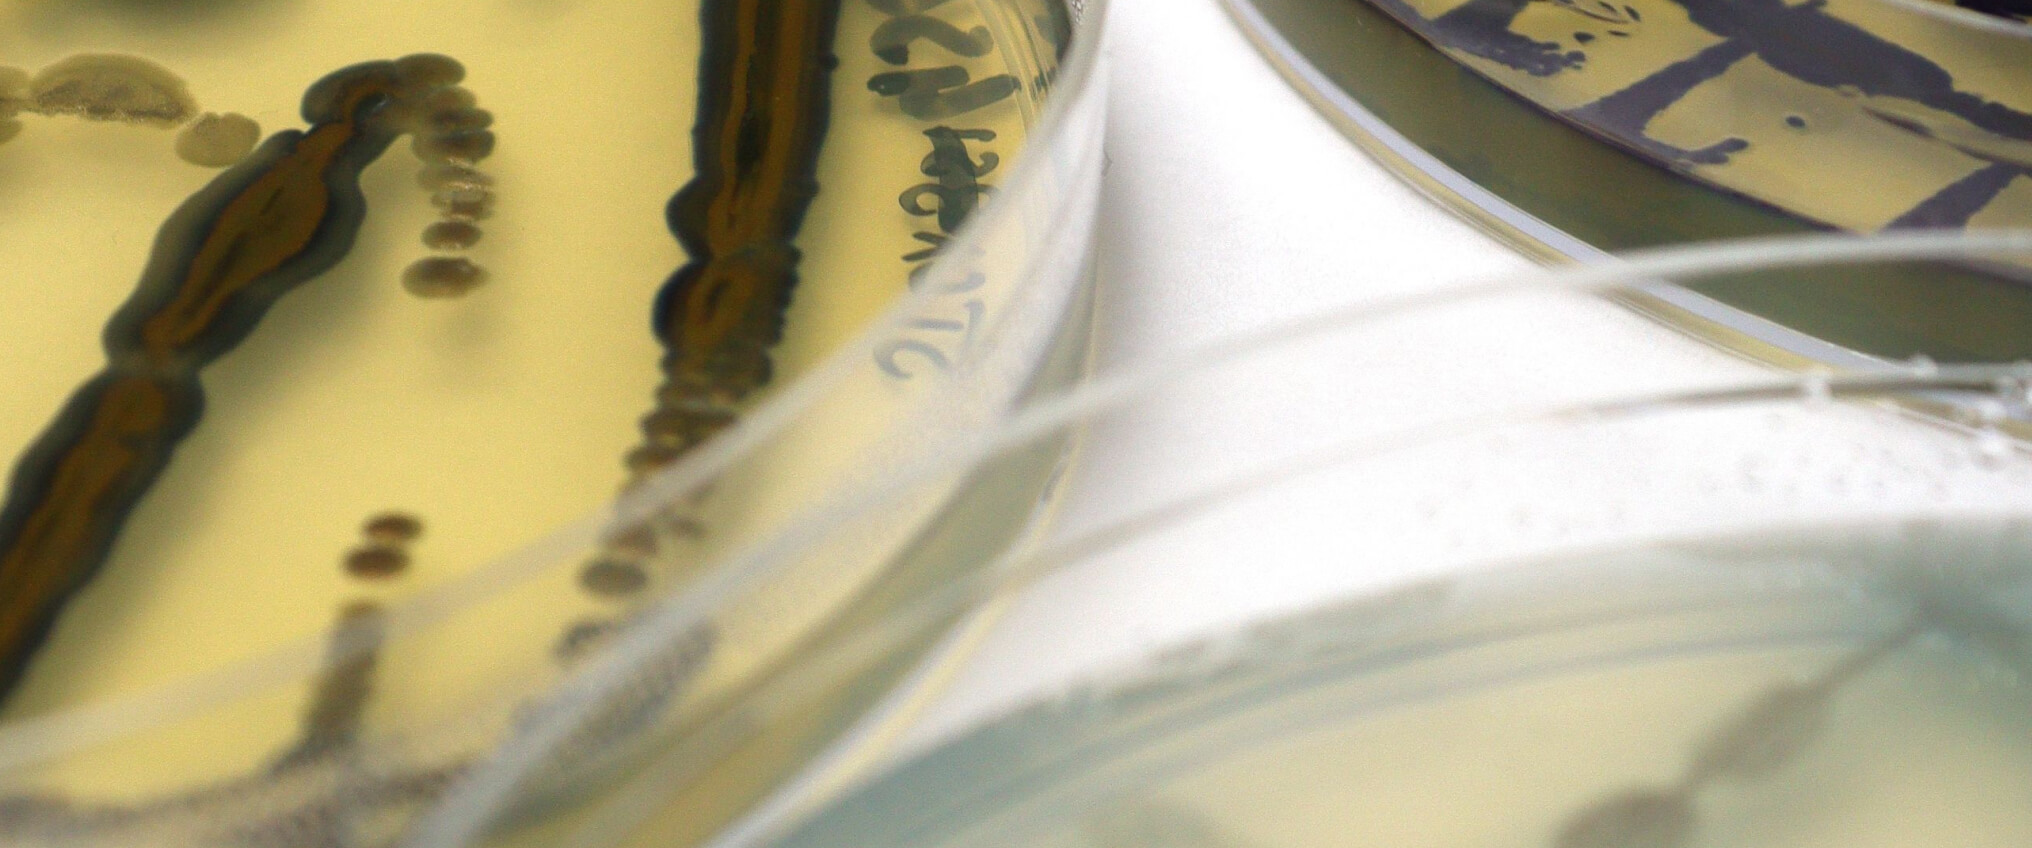
Close up photo of the biobased dyeing process

Colorifix, a UK-based biotech company, aims to eliminate the negative impacts on biodiversity and human health caused by conventional dyeing textile dyeings. The Colorifix dyeing process moves away from toxic petrochemicals and other harmful substances. Instead, they have developed an entirely biology-based process to produce, deposit, and fix pigments onto textiles. Via online DNA sequencing, they can identify and replicate the colour information found in a living organism such as an animal, plant or microbe. They then insert that information into a non-pathogenic microbe. Using renewable feedstocks such as sugars, yeasts, and plant by-products, they grow these microorganisms that can not only produce the desired colour but also transfer it onto clothing with zero harmful substances and a fraction of the water and energy necessary in conventional dyeing.
Their solution has already received the support of big players in the sector, like Fashion for Good. The first collection using their technology was launched by H&M in early 2021.
Biodiversity benefits
Compared to conventional dyeing, Colorifix says its process requires up to 90% less water and 70% less energy, as well as eliminating the use of hazardous chemicals, therefore reducing the potential harm to natural environments.
This page is part of a deep dive into biodiversity and fashion, where we delve deeper into safeguarding biodiversity by circulating clothes, eliminating pollution, and regeneratively growing natural fibres.